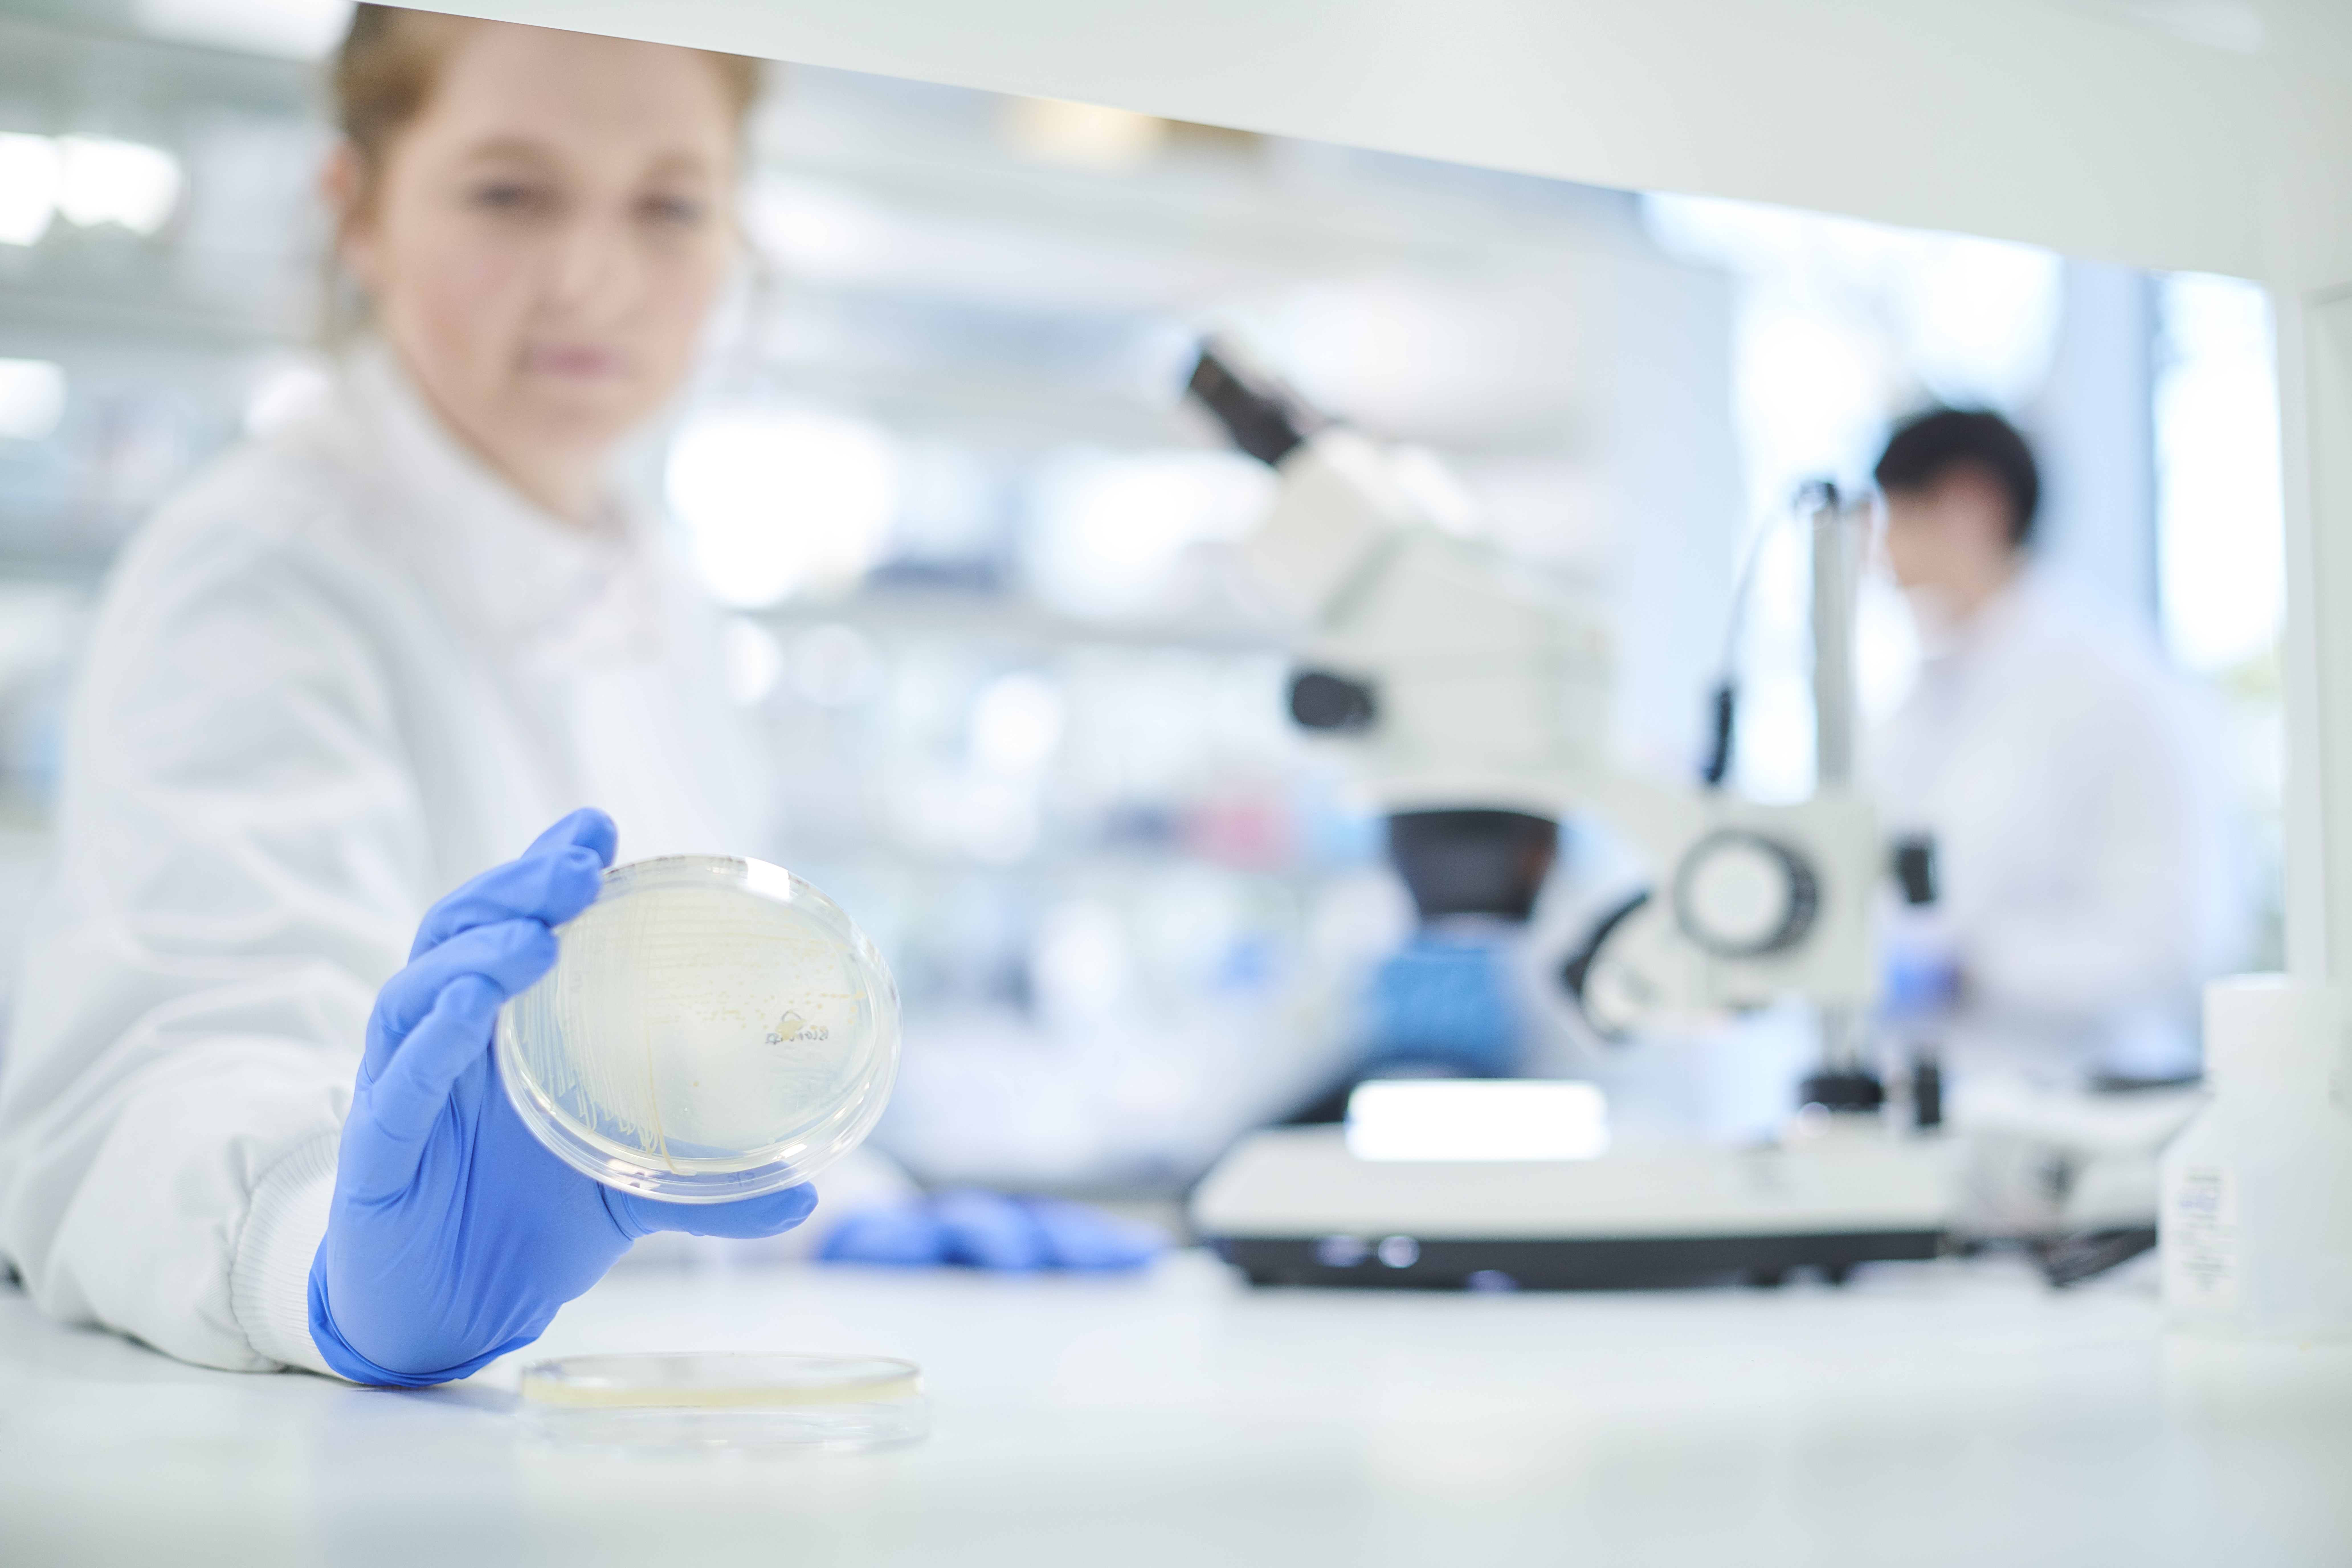

Elektronik/Läkemedelsindustri
Elektronik- och läkemedelsindustrin arbetar i miljöer där minsta avvikelse kan påverka produktkvalitet. Här krävs avancerad ventilation, noggrann temperaturstyrning, rätt tryckförhållanden och tekniska system som presterar med extrem tillförlitlighet. Samtidigt ökar behovet av energieffektiva lösningar, spårbar data och modern automationsstyrning.

Vanliga kundutmaningar
- Krav på renrum, kontrollerade zoner och stabila tryckförhållanden
- Minimala toleranser för temperatur och luftkvalitet
- Hög energianvändning från ventilation, kyla och filtrering
- Processer som är känsliga för vibrationer, klimatvariationer och driftstopp
- Behov av avancerad dokumentation och spårbarhet vid revisioner
- Stora mängder data som måste vara tillgängliga och tillförlitliga
- Äldre teknik som inte klarar dagens krav på precision och uppkoppling
- Krav på långsiktig stabilitet för både produktion och produktkvalitet

Precision, kontroll och hög driftsäkerhet
Ömangruppen optimerar ventilation, kyla, värme och styrsystem för att upprätthålla stabila tryckförhållanden, rätt temperatur och filtrerad luft i varje zon – från renrum till produktionslokaler och labb.
Genom uppkopplade system och tydlig energidata får du full kontroll över förbrukning, avvikelser och driftstatus. Vi arbetar kontinuerligt med service, trimning och teknisk optimering för att minimera driftstörningar och säkerställa att processerna löper stabilt över tid.
Vi stödjer även verksamheten i kraven på dokumentation, spårbarhet och rapportering, och hjälper till att planera moderniseringar och förbättringar som framtidssäkrar anläggningen. Resultatet blir en mer förutsägbar drift, högre produktsäkerhet och lägre energiförbrukning – utan att kompromissa med precisionen.
Resultat du märker
- Stora förbättringar även av små åtgärder. Mindre justeringar i drift och styrning ger ofta märkbar skillnad – utan stora investeringar.
- Stabilt och jämnt inomhusklimat. Optimerade system innebär att de är mer effektiva.
- Minskade underhållskostnader. Färre driftstörningar och bättre kontroll minskar oftast behovet av akuta insatser och onödigt slitage.
- Bättre driftnetto. Lägre driftkostnader och mer förutsägbar drift bidrar positivt till fastighetens ekonomi på både kort och lång sikt.
PropTech Connect
Vår tjänst PropTech Connect gör det möjligt att arbeta systematiskt och datadrivet med din fastighets energiförbrukning. Den gör det enklare att uppfylla alla de lagkrav som finns och prioritera rätt åtgärder.
Tjänsten är webbaserad och uppdelad i tre segment. Du kan själv välja vilka delar du behöver.
PropTech Connects tre delar:
- Drift – teknisk styrning och stabilitet
- Energi – insamlad, strukturerad och användbar energidata
- Prognos – bättre beslut, planering och långsiktighet
Du väljer också själv vilken nivå som passar dig – Brons, Silver eller Guld – och kan öka på när fastigheten behöver mer.

"Jag värdesätter särskilt våra uppföljningsmöten där vi hittar bra lösningar tillsammans."
Martin Grundén, Hanter Ingenjörsteknik
Vi anpassar våra tjänster efter din bransch
Våra tjänster för Elektronik/Läkemedelsindustri
Våra kunder berättar
I över 30 år har Ömangruppen hjälpt kunder energieffektivisera och hitta tekniska lösningar till sina fastigheter. Läs mer om samarbetet med några av våra kunder och partners.